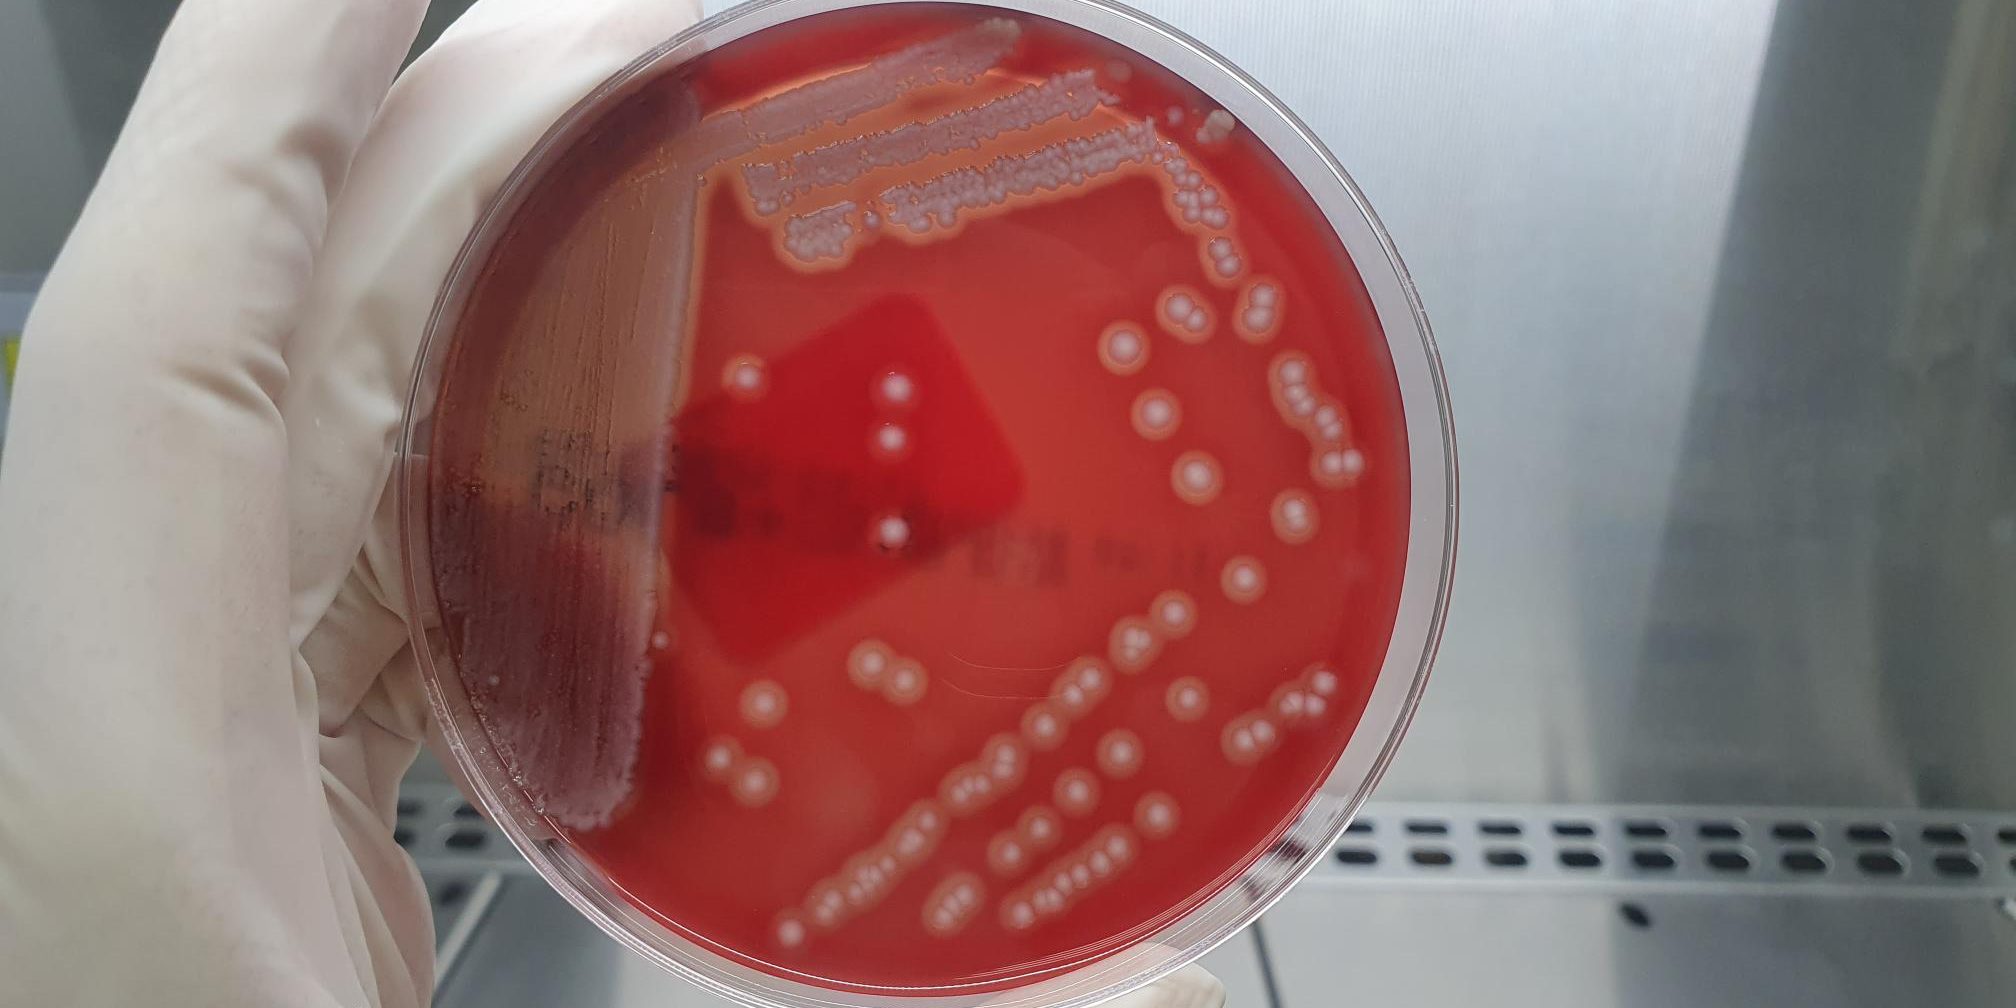

Escherichia coli beta hemolítico es una bacteria patógena que afecta principalmente a lechones neonatos y destetados, provocando cuadros graves de diarrea y septicemia. Su capacidad de hemólisis, es decir, la destrucción de glóbulos rojos, le confiere una mayor virulencia y agrava el impacto de la infección.
Los signos clínicos más comunes incluyen diarrea profusa de aspecto acuoso o amarillento, que rápidamente provoca deshidratación severa, pérdida de apetito y, en los casos más graves, septicemia, lo que puede derivar en la muerte súbita de los lechones y una alta tasa de mortalidad. Esta enfermedad compromete seriamente el crecimiento de los animales y genera pérdidas económicas significativas debido a la necesidad de tratamientos veterinarios y medidas de control.
Para prevenir y controlar la enfermedad, es fundamental aplicar estrictas medidas de bioseguridad en las granjas, asegurando condiciones higiénicas óptimas para minimizar la propagación de la bacteria. Un diagnóstico rápido y preciso es clave para detectar la presencia de E. coli beta hemolítico y actuar a tiempo.
En Zenit, ofrecemos resultados en un máximo de 48 horas, garantizando rapidez y fiabilidad en la detección para que puedas tomar las mejores decisiones en la gestión sanitaria de tu explotación.